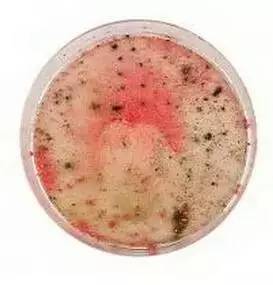

旧化妆品舍不得扔?别小气了!否则得不偿失。它们可能藏匿着细菌,有的还能够引起危及生命的脑膜炎!太可怕了!

四分之一的女性,
一只睫毛膏会使用一年
但睫毛膏9个月就会过保质期

五分之一的女性,
一瓶洁面乳用12个月
但这是建议使用期限的两倍

还有十分之一的人,
口红会用上超过三年
其实两年就已经超过保质期了……
看看你的化妆品里藏着哪些细菌……

伦敦城市大学的研究人员测试了五种产品,包括腮红、粉底和唇彩。他们竟然发现了五种致命细菌!
真杆菌——会导致细菌性阴道炎
气单胞菌属——会导致肠胃炎和伤口感染
表皮葡萄球菌——一种会对抗生素产生耐药性的细菌,对本身有疾病的人来说可能会致命
痤疮丙酸菌属——是导致痤疮和其他皮肤问题的主要原因
肠杆菌属——对于免疫系统受损的人来说,可能引起泌尿系统和呼吸道感染

唇膏
放置两年11个月(过期10个月)
检测呈脑膜炎细菌阳性

睫毛膏
放置10个月(过期4个月)
检测呈肠杆菌属和真杆菌阳性
腮红
放置1年10个月(过期9个月)
检测发现脑膜炎细菌阳性

唇彩
放置1年(2016年8月过期)
检测呈脑膜炎细菌阳性

粉底
放置1年5个月(过期4个月)
检测呈脑膜炎细菌阳性
不止这些
↓ ↓ ↓
↓ ↓ ↓
↓ ↓ ↓
在测试腮红、粉底和唇彩等5种化妆品后,研究人员在这些化妆品上发现了粪肠球菌——脑膜炎的主要致病原因之一。 还发现了丙酸杆菌,是导致痤疮和其他皮肤问题的主要原因之一。使用化妆品有几点要注意一、不要同时使用多个厂家的产品

擦抹不同厂家生产的化妆品,在人体肌肤上容易引起化学反应。一般说来,最好是选择同一厂家生产的系列化妆品。二、不要使用已过保质期的化妆品

化妆品中很多成分时间长了就会分解、变化,极易引起皮肤损伤。三、不要过量使用化妆品

因皮肤有其自身的代谢规律,过厚的脂粉会堵塞毛孔,影响皮肤的正常“呼吸”。四、不要过分追求疗效

警惕这些化妆品可能含有激素。按规定,现在的化妆品都需要详细标注所含的成分,常见的标有“松”的成分,通常表示含有激素。五、不要迷信天然产品

天然产品也有致敏感的成分。六、不要用手指挑化妆品。

化妆工具要勤洗勤换,如果不注意卫生,就会引起化学反应而导致化妆品的变质。
(来源:法制晚报)

